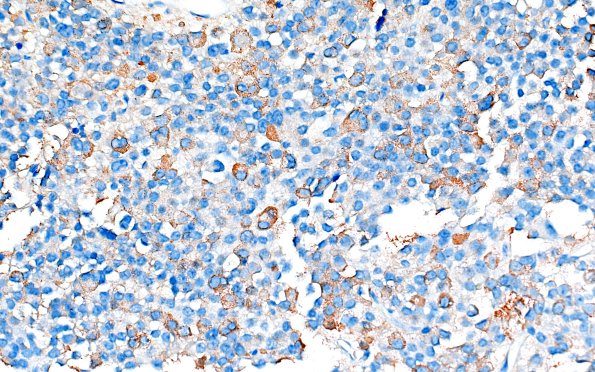
8C1 Adenoma, GH (Case 8) GH 40X 1

Table of Contents
Washington University Experience | NEOPLASM (SELLAR) | Pituitary Adenoma - Pituitary Neuroendocrine Neoplasm | Somatotroph | 8C1 Adenoma, GH (Case 8) GH 40X 1
8C1,2 Tumor cells are positive for GH, but are sparsely granulated. (GH IHC)